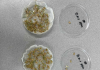

군산시, 도서관주간 맞아 특별 문화 프로그램 운영
4월 12일부터 18일까지 ‘두 배로 대출’ 등 다양한 독서문화 행사 진행
작가 초청·공연·체험 프로그램으로 시민 참여 확대
작가 초청·공연·체험 프로그램으로 시민 참여 확대
오승택 기자입력 : 2026. 04. 09(목) 09:22

군산시, 도서관주간 맞아 특별 문화 프로그램 운영
[시사종합신문 = 오승택 기자] 군산시는 도서관의 가치와 필요성을 시민들과 공유하고, 지역 내 도서관 이용 활성화를 위해 4월 ‘도서관주간 특별 문화 프로그램’을 운영한다고 밝혔다.
매년 4월 12일부터 18일까지 진행되는 도서관주간은 1964년 시작된 이후 60여 년간 이어져 온 대표적인 독서문화 캠페인이다.
이번 도서관주간(4.12.~4.18.) 동안 군산시 모든 공공도서관(본관, 분관, 작은도서관 포함)에서는 시민들이 책과 함께 풍성한 봄을 즐길 수 있도록 ‘두 배로 대출’ 프로그램을 운영한다. 이를 통해 기존 1인당 5권이던 대출 권수를 최대 10권까지 확대한다.
각 도서관별 주요 프로그램을 살펴보면, 먼저 군산시립도서관은 4월 15일 ‘친구의 전설’의 이지은 동화작가를, 16일에는 ‘구의 증명’의 최진영 작가를 차례로 초청해 시민들과 문학적 교감을 나누는 시간을 마련한다. 이와 함께 나만의 대출증 꾸미기, 우리 도서관 그림 그리기, 고전 공동 필사 프로그램 등 체험형 프로그램도 함께 운영해 시민 참여를 유도할 계획이다.
금강도서관에서는 ‘민병권 그림책 작가와의 만남’을 통해 어린이와 작가가 직접 소통하는 자리를 마련한다. 또한 학부모를 대상으로 ‘세 박사가 들려주는 그림책 사용 설명서’ 특강을 총 3회에 걸쳐 진행하며, 외국 어린이 도서 전시, 블라인드북, 도서관 이용 엽서 컬러링 등 다양한 부대 프로그램도 운영한다.
늘푸른도서관은 어린이와 가족 단위 이용자를 위한 프로그램을 중심으로 운영된다. 4월 14일에는 아동 및 보호자 90명을 대상으로 입체낭독극 ‘안녕, 나의 고래, 나는 개다’를 선보이며, 18일에는 초등학생 30명을 대상으로 ‘황선애 작가와의 만남’과 ‘오리 부리 이야기’ 독후활동을 진행한다. 이 밖에도 우리가족을 소개합니다, 마음이 열리는 독서나무 등 따뜻한 참여 프로그램이 마련되어 있다.
설림도서관은 4월 17일 아동 및 보호자 50명을 대상으로 ‘더캔들 애니메이션 영화 OST 콘서트’를 개최해 색다른 문화 경험을 제공할 예정이다. 아울러 나만의 도서관 포스터 제작, 동화 주인공 그리기, 책 속 한 줄 뽑기 등 다양한 체험 프로그램도 함께 운영한다.
산들도서관에서는 보드게임 체험과 독후활동지 체험, 블라인드북 프로그램을 통해 시민들에게 색다른 독서 경험과 즐거움을 제공할 계획이다.
최지선 도서관관리과장은 “이번 도서관주간을 통해 시민들이 일상 속에서 도서관의 가치를 재발견하고, 책과 함께 소통하며 힐링하는 시간을 보내길 바란다”며 “앞으로도 지역 주민들이 도서관을 더욱 친숙하게 느낄 수 있도록 다양한 프로그램을 지속적으로 마련하겠다”고 밝혔다.
자세한 사항은 군산시립도서관 누리집을 참조하거나 ☎454-5620으로 문의하면 된다.
매년 4월 12일부터 18일까지 진행되는 도서관주간은 1964년 시작된 이후 60여 년간 이어져 온 대표적인 독서문화 캠페인이다.
이번 도서관주간(4.12.~4.18.) 동안 군산시 모든 공공도서관(본관, 분관, 작은도서관 포함)에서는 시민들이 책과 함께 풍성한 봄을 즐길 수 있도록 ‘두 배로 대출’ 프로그램을 운영한다. 이를 통해 기존 1인당 5권이던 대출 권수를 최대 10권까지 확대한다.
각 도서관별 주요 프로그램을 살펴보면, 먼저 군산시립도서관은 4월 15일 ‘친구의 전설’의 이지은 동화작가를, 16일에는 ‘구의 증명’의 최진영 작가를 차례로 초청해 시민들과 문학적 교감을 나누는 시간을 마련한다. 이와 함께 나만의 대출증 꾸미기, 우리 도서관 그림 그리기, 고전 공동 필사 프로그램 등 체험형 프로그램도 함께 운영해 시민 참여를 유도할 계획이다.
금강도서관에서는 ‘민병권 그림책 작가와의 만남’을 통해 어린이와 작가가 직접 소통하는 자리를 마련한다. 또한 학부모를 대상으로 ‘세 박사가 들려주는 그림책 사용 설명서’ 특강을 총 3회에 걸쳐 진행하며, 외국 어린이 도서 전시, 블라인드북, 도서관 이용 엽서 컬러링 등 다양한 부대 프로그램도 운영한다.
늘푸른도서관은 어린이와 가족 단위 이용자를 위한 프로그램을 중심으로 운영된다. 4월 14일에는 아동 및 보호자 90명을 대상으로 입체낭독극 ‘안녕, 나의 고래, 나는 개다’를 선보이며, 18일에는 초등학생 30명을 대상으로 ‘황선애 작가와의 만남’과 ‘오리 부리 이야기’ 독후활동을 진행한다. 이 밖에도 우리가족을 소개합니다, 마음이 열리는 독서나무 등 따뜻한 참여 프로그램이 마련되어 있다.
설림도서관은 4월 17일 아동 및 보호자 50명을 대상으로 ‘더캔들 애니메이션 영화 OST 콘서트’를 개최해 색다른 문화 경험을 제공할 예정이다. 아울러 나만의 도서관 포스터 제작, 동화 주인공 그리기, 책 속 한 줄 뽑기 등 다양한 체험 프로그램도 함께 운영한다.
산들도서관에서는 보드게임 체험과 독후활동지 체험, 블라인드북 프로그램을 통해 시민들에게 색다른 독서 경험과 즐거움을 제공할 계획이다.
최지선 도서관관리과장은 “이번 도서관주간을 통해 시민들이 일상 속에서 도서관의 가치를 재발견하고, 책과 함께 소통하며 힐링하는 시간을 보내길 바란다”며 “앞으로도 지역 주민들이 도서관을 더욱 친숙하게 느낄 수 있도록 다양한 프로그램을 지속적으로 마련하겠다”고 밝혔다.
자세한 사항은 군산시립도서관 누리집을 참조하거나 ☎454-5620으로 문의하면 된다.